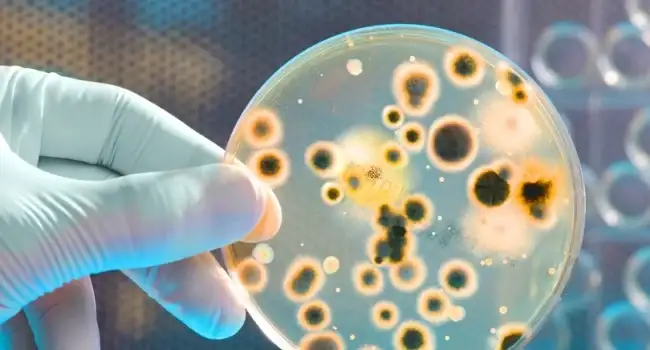

Ապրիլի 21-ին Բյուրեղավան համայնքում արձանագրվել են աղիքային վարակիչ հիվանդության դեպքեր, որոնց առթիվ նախաձեռնվել է քրեական վարույթ Araratnews-ին հայտնեցին քննչական կոմիտեից։
«Նախաձեռնվել է քրեական վարույթ՝ ՔՕ-ի 412-րդ հոդվածի 1-ի մասի (անվտանգության պահանջներին չհամապատասխանող հումքերի կամ ապրանքների շրջանառությունը, աշխատանքների կատարումը կամ ծառայությունների մատուցումը) հատկանիշներով»,-ասացին կոմիտեից։
